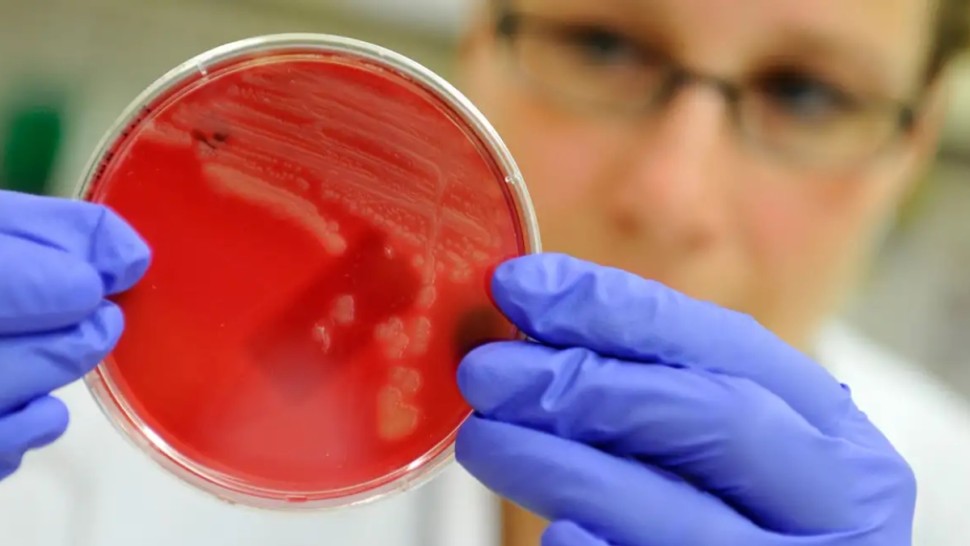
مضادات حيوية

تونس تعتمد الرقمنة والذكاء الاصطناعي لمواجهة تحدي مقاومة المضادات الحيوية
وأكد مصطفى الفرجاني أن مقاومة المضادات تشكل تحديًا وطنيًا مشتركًا يستدعي التنسيق بين كل القطاعات وفق نهج الصحة الواحدة (One Health).
وتم خلال الجلسة، الاتفاق على جملة من الإجراءات الهامة، شملت تعزيز تبادل البيانات بين الهياكل المعنية، كما تم الاتفاق على اعتماد الرقمنة والذكاء الاصطناعي في عمليات الرصد والتقصي لمقاومة البكتيريا.
وتضمنت الإجراءات المتفق عليها كذلك دعم تكوين الإطارات الصحية والبيطرية وتطوير قدرات المخابر البشرية والحيوانية.
إضافة إلى ذلك، تقرر تشجيع البحث العلمي في هذا المجال، والعمل على ترشيد استعمال المضادات الحيوية للحد من تطور المقاومة.






